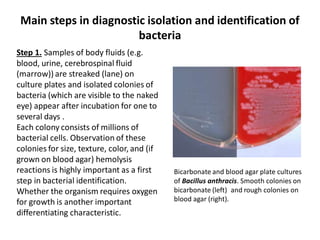
Main steps in diagnostic isolation and identification of
bacteria
Step 1. Samples of body fluids (e.g.
blood, urine, cerebrospinal fluid
(marrow)) are streaked (lane) on
culture plates and isolated colonies of
bacteria (which are visible to the naked
eye) appear after incubation for one to
several days .
Each colony consists of millions of
bacterial cells. Observation of these
colonies for size, texture, color, and (if
grown on blood agar) hemolysis
reactions is highly important as a first
step in bacterial identification.
Whether the organism requires oxygen
for growth is another important
differentiating characteristic.
Bicarbonate and blood agar plate cultures
of Bacillus anthracis. Smooth colonies on
bicarbonate (left) and rough colonies on
blood agar (right).

This document provides an overview of microorganisms and bacteria. It discusses that microorganisms are unicellular or multicellular organisms that include bacteria, fungi, algae, protozoa, and viruses. Bacteria are specifically unicellular prokaryotic organisms that lack membrane-bound organelles. The document describes bacterial cell structure both inside and outside the cell wall, including shapes, flagella, pili, capsules, cell membrane, cytoplasm, nucleoid, plasmids, and ribosomes. It also discusses endospore formation in certain bacteria.